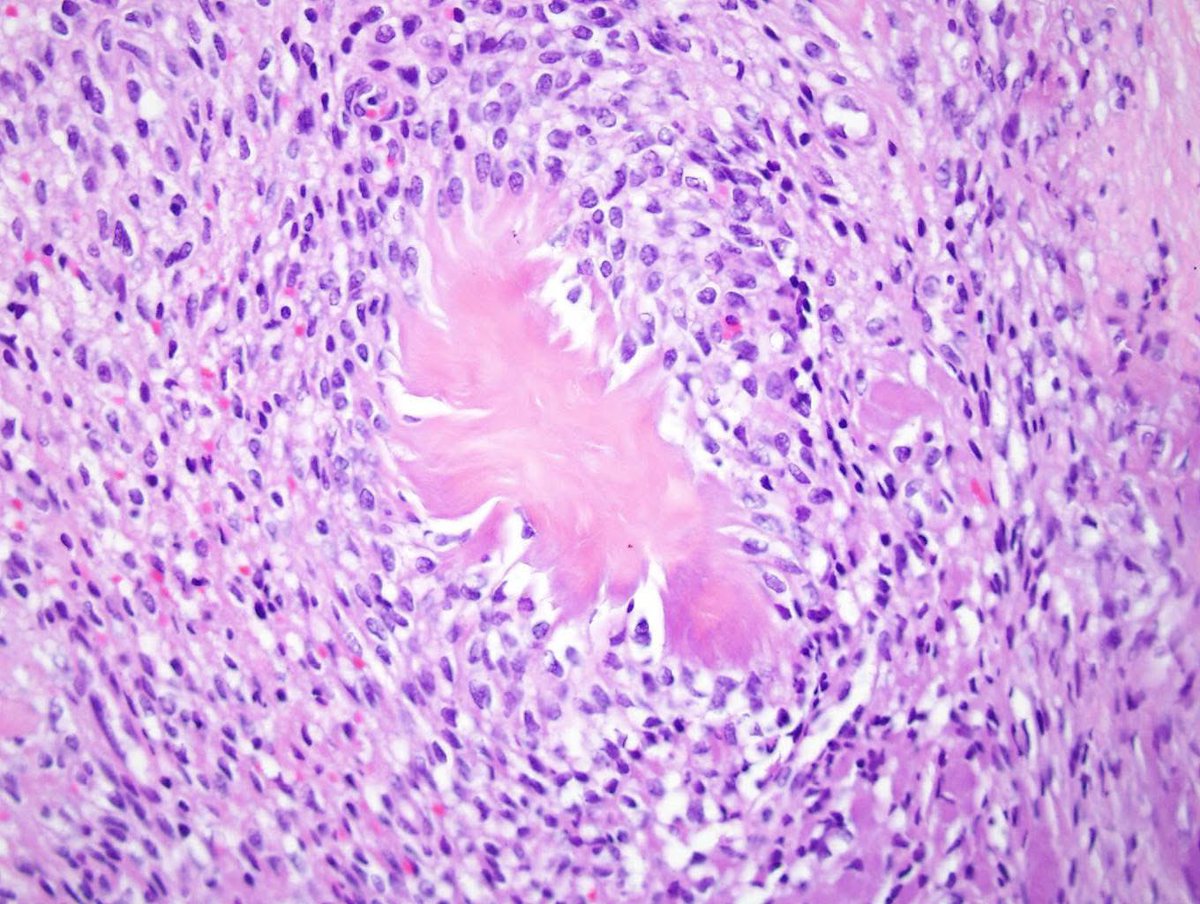
Kalyani Bambal tweet media

Dr Rebecca Morrow (her/she) รีทวีตแล้ว
Dr Rebecca Morrow (her/she)
775 posts

Dr Rebecca Morrow (her/she)
@RMorrowPath
AP with a keen interest in GYN and H&N pathology, all things molecular, teaching and training, and positive workplace culture. #gynpath #entpath #pathtwitter
Adelaide, South Australia เข้าร่วม Haziran 2023
518 กำลังติดตาม786 ผู้ติดตาม
Dr Rebecca Morrow (her/she) รีทวีตแล้ว

No, it’s not a choroid plexus tumor! When metastatic lung adeno mimics choroid plexus. Frontal lobe, adult. A big clue is WRONG location! TTF-1/NapsinA is shown #Pathtwitter #Pathx #neuropath #neuropathology #cnspathology




English
Dr Rebecca Morrow (her/she) รีทวีตแล้ว

A microphone and an occasion to talk pathology? Yes please!! Thanks for the opportunity Alecia and Cherie 🤩#gynpath #endometriosis #endountangled

English

Brilliant talk from Dr. Ana Felix on unusual tumours of the cervix. Thanks @BAGPGynPath for making the recording available to enable watching it in day light hours! #gynpath #pathology

English
Dr Rebecca Morrow (her/she) รีทวีตแล้ว

Barnaculate Carcinoma in Four Patients: Verrucoid Squamous Cell Carcinoma Subtype with TERT and HRAS Oncogenic Variants
Liang, Afkhami, Thompson, et al.
rdcu.be/e2l4y
#HeadNeckPathol #HNPJ #HeadandNeckPath #Pathology #ENTPath #PathologyTweet


Français
Dr Rebecca Morrow (her/she) รีทวีตแล้ว

An Institutional Experience of Core Needle Biopsy with Cooperative Implementation by Pathologists and Head and Neck Oncologists in Salivary Gland Carcinoma
Kobayashi, Yoshimoto ...
rdcu.be/eXlQB
#HeadNeckPathol #HNPJ #HeadandNeckPath #Pathology #ENTPath #PathologyTweet




English
Dr Rebecca Morrow (her/she) รีทวีตแล้ว

Novel Glomeruloid Adenocarcinoma Arising in the Mandible Harboring EWSR1::YY1
Daniel L. Miller, Justin A. Bishop & Louis P. Dehner
rdcu.be/eXlPZ
#HeadNeckPathol #HNPJ #HeadandNeckPath #Pathology #ENTPath #PathologyTweet


English

Thanks @kimballscott for sharing your wisdom and experience.
#radicalcandor was one of the most thought provoking and high impact reads of 2025 for me as a #medicalleader

English
Dr Rebecca Morrow (her/she) รีทวีตแล้ว

📢 One-Day Virtual Meeting – 6 March 2026
Topic: Cervical Pathology – Pitfalls and Difficulties
🧠 Expert talks, live cases, and key updates on IHC pitfalls, HPV testing, staging challenges, glandular lesions, unusual SCC presentations & rare entities.
🎥 Can’t attend live? Get 3 months of on-demand access to all recordings and materials.
📄 Certificate of attendance included.
👉 Register now: thebagp.org/event/cervical…
#Gynaepath #GynPath #PathTwitter

English
Dr Rebecca Morrow (her/she) รีทวีตแล้ว

Ever thankful for a new year with a brief slow down of #pathology cases to enable reflection on 2025, and planning for 2026. Enjoy your holidays surgeons, may they be long and restful 😜!! #medicalleadership

English
Dr Rebecca Morrow (her/she) รีทวีตแล้ว

New in #HumPathol: Endometrial Carcinomas – Challenges and Updates on Selected Topics. sciencedirect.com/science/articl… #pathology #PathTwitter #PathX #GYNpath

English

After a long Twitter hiatus because... life... I'm back to bring you this endometrial lesion in a 42 yo woman with abnormal uterine bleeding. Hysteroscopy showed an endometrial polyp in the lower uterine segment #GynePath #GynPath #PathTwitter



English

@JojoPathAdvntrs @RibianszkyA Beautiful! Thanks for sharing
English


Is there any better gift to the #pathologist and patient than a suspicious skin lesion which turns out to be a seb k??? #pathology

English
Dr Rebecca Morrow (her/she) รีทวีตแล้ว
Dr Rebecca Morrow (her/she) รีทวีตแล้ว

A rectal biopsy showing metastatic endometrial stromal sarcoma with 😎 💥 burst collagen and positive ER stain.Credits:ARP Press.@DrMarkOng
@smlungpathguy @pepeheffernan @SumantaDas_7 @MirunaPopescu13 @DanGrahamMD @Venkateshgilly2 @drtimbracey @GIJamesMD @kis_lorand

English
Dr Rebecca Morrow (her/she) รีทวีตแล้ว



















